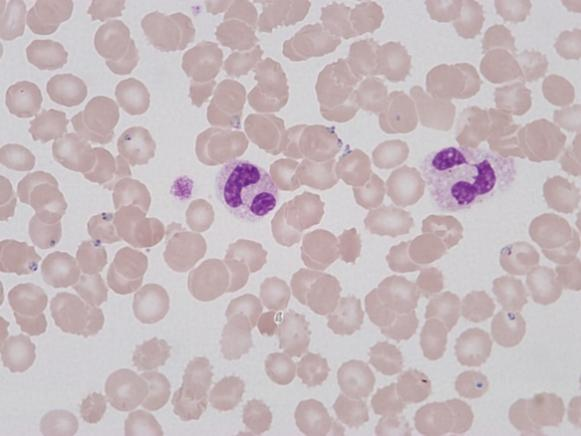

微信掃描二維碼,點擊右上角 ··· 按鈕
轉發給朋友或分享到朋友圈

正置生物顯微鏡ML45
聯系客服生物顯微鏡 ML45采用無限遠光學系統,標準LED科勒照明,可實現明場觀察,光路拓展性強,可升級暗場、相差、偏光、熒光多種顯微觀察方式;智能化整機系統設計,ECO功能人走燈滅,智能節能;明場白光照明色溫可調并可記憶;帶USB程控,可USB供電。5孔編碼物鏡轉盤,明場亮度記憶功能,物鏡多倍數多種類可選配。
智能化系統
功能拓展性極強
高清晰、高還原度成像

留言
微信掃描二維碼,點擊右上角 ··· 按鈕
轉發給朋友或分享到朋友圈